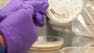
Preclinical Safety

In collaboration with Davidson College, this specialization is intended for a graduate level audience with a life sciences background seeking to learn about preclinical drug discovery.
Preclinical drug discovery is a complex, challenging, and iterative hunt for novel new medicines to address the unmet medical needs of patients. The science and considerations behind this endeavor are covered in this online specialization composed of 6 courses, which begins with an Introduction to Drug Hunting, followed by in-depth discussions of Targets, Assays and Screening, Lead Selection and Optimization, Pharmacokinetics, Preclinical Safety, and Preformulation. The specialization is self-paced, with each course comprised of short 5-minute videos covering selected topics, accompanied by additional readings and problems designed to reinforce and deepen understanding of those topics.
Projet d'apprentissage appliqué
Learners will develop their knowledge of preclinical drug discovery through a combination of short 5-minute videos covering selected topics, accompanied by additional readings and problems designed to reinforce and deepen understanding of those topics.